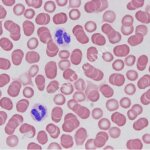

咖啡因(Caffeine)檢測試劑盒 | Creative Diagnostics貨號Cat#DEIA6842

桌上型離心機 | DSC-200T離心機系列 貨號DSC-200T

Ac-DEVD-CHO| Caspase-3 Inhibitor I, N-Ac-Asp-Glu-Val-Asp-CHO Selleckchem貨號S7901

桌上型離心機 | 6000rpm經濟型離心機 DSC-200D (附轉盤UAR-1508, 型號DSC-200D)
Wright-Giemsa Staining Kit | 血液(blood)和骨髓( bone marrow )塗片的染色劑貨號G1007-250ML

人髓過氧化物酶 (Myeloperoxidase, MPO) ELISA 試劑盒 | Coon Koon貨號CK-bio-12559

丙二醛 (Malondialdehyde, MDA) ELISA試劑盒 | 貨號CK-bio-29577

大鼠 INS(胰島素)ELISA試劑盒 -ELK Biotechnology貨號ELK2370

大鼠 I-PTH(甲狀旁腺激素) ELISA試劑盒 -ELK Biotechnology貨號ELK2563

大鼠 ALP(鹼性磷酸酶)ELISA 試劑盒 -ELK Biotechnology貨號ELK5657
